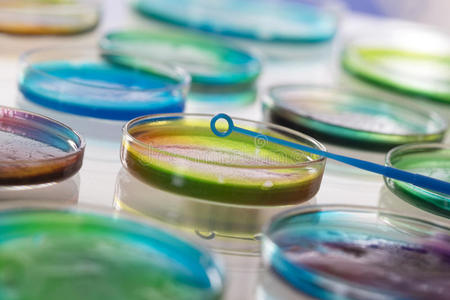
细菌培养图片-细菌培养素材-细菌培养插画-摄图新视界

微生物培养

细菌培养基,细菌培养所需组分索引,培养基知识问答库,青岛日水微生物
图片尺寸598x447
微生物学家手培养培养皿白衣接种循环,在高压釜旁边照片-正版商用图片
图片尺寸700x467
【12.8】细菌,真菌观察培养——黑格尔老师带你开启微生物世界-在线订
图片尺寸550x550
越来越多的病毒和细菌细胞的培养皿.微生物
图片尺寸1024x713
各种微生物菌在培养基下的图片#农业种植 #心系三农服务三农 - 抖音
图片尺寸1159x1080
女科学家拿着培养皿在营养琼脂上的土壤微生物.
图片尺寸1200x800
大家帮我看看培养皿是什么菌啊 - 食品微生物检测 - 食品论坛 - power
图片尺寸2560x1920
微生物图片-微生物图片大全-微生物高清图片下载
图片尺寸525x350
【二手9成新】现代微生物培养基和试剂手册【扉页字迹】 /谢正栘,吴挹
图片尺寸1200x1600
皮氏培养皿,垂直画幅,生物科技,微生物学,手
图片尺寸800x1200
培养皿_细菌_培养_检查_颠倒_亮光_显微镜_微生物学_实验室_图片大全
图片尺寸794x596
mrs培养基的细菌形态 - 食品微生物检测 - 食品论坛 - powered by dis
图片尺寸4160x3120
微生物图片1--大肠杆菌系列 - 食品微生物检测 - 食品论坛 - powered
图片尺寸2816x2112
科学网—谁开创了微生物纯培养技术 - 马桥的博文
图片尺寸827x828
细菌培养
图片尺寸1200x800
淋球菌图片-淋球菌素材-淋球菌插画-摄图新视界
图片尺寸450x300
不同的细菌和霉菌菌落生长在有营养琼脂的培养皿上
图片尺寸1200x795
美国首届微生物培养皿艺术大赛ppt模板 - 当图网
图片尺寸1200x5800
细菌培养图片壁纸 第9页-高清背景图-zol桌面壁纸
图片尺寸960x600
细菌培养图片-细菌培养素材-细菌培养插画-摄图新视界
图片尺寸450x300